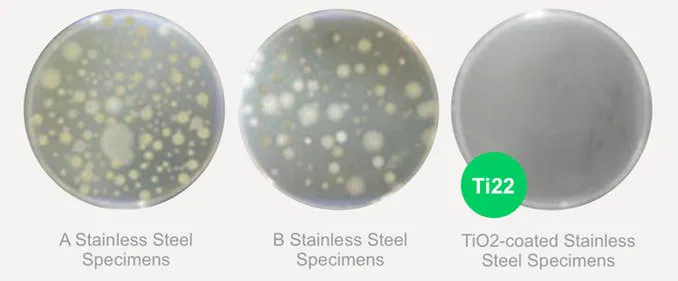

ポケットサイズの純チタン製真空サーモボトル「Micro Therma」とは

「Micro Therma」は、Kickstarterとmachi-yaのキャンペーンで爆発的人気を博し、3200万円の支援を集めたチタン製ボトル「Therma」(サーマ)のポケットサイズモデル。チタン製品の専門ブランドである「TITANO(チタノ)」が日本向けに開発した特別なボトルです。
ステンレスのサーマボトルにはつきものの金属臭ですが、医療現場で使用されるグレードの高純度チタンを使った「Micro Therma」は、純チタンでできているため無味無臭。飲み物の繊細な香りをそのまま楽しむことができます。

ステンレス製よりも軽く、ポケットに入れてどこにでも持っていけるサイズなうえに、強度が強く腐食しにくいので破損や錆びともほぼ無縁。独自の真空二重構造で設計されたサーモボトルです。

素材の味を楽しむ金属ボトル
「Micro Therma」に使われている素材は医療グレードの純チタンであり、衛生面に優れているだけでなく、食べ物・飲み物の風味を変えない素材としても注目を集めています。

純チタンの実力は、国内のミシュラン掲載店がカトラリーの導入を決めるほど。高級なお酒や、繊細な味を楽しむスペシャルティコーヒーを味わうにも最適です。
チタンらしいマットな表面加工
ボトル本体はチタンらしいマットな仕上げ処理が施されています。金属素材とはいえ、光沢が控えられているため、目立ちすぎず、主張しすぎない高級感を楽しむことができます。

高機能なカップとして

「Micro Therma」はちょうどカップ1杯ほどの用量で、普段使いのカップの代わりに使うのにもちょうど良いサイズ。

場所も取らず、仕事の場所を変えるときも、家の中で別の部屋に移動するときも、ポケットに入れて持ち歩くことができます。

背面には転倒防止のシリコン加工がしてあるため、デスクで倒してPCに飲み物がかかる心配もありません。

純チタンが持つ、天然の抗菌性
チタンは空気に触れると、チタン原子の非常に薄い層が酸素と相互作用して、酸化チタン(IV)またはチタニアとしても知られるTiO2(二酸化チタン)のナノコーティングを生成します。このチタニア(TiO2)には、細菌の繁殖を防ぐ天然の抗菌性があります。

そのため、ステンレス、アルミニウム、プラスチックのボトルに入れた場合と比べて、チタン製のボトルにミルクコーヒーを入れると、最大3倍長持ちします。

以下は、ペトリ皿に一般的なステンレス鋼標本2種類(AとB)とチタニア(TiO2)をコーティングしたステンレス鋼標本を置いて24時間経過した時点での細菌と大腸菌コロニーの繁殖状態を示しています。大差は歴然です。
細菌
大腸菌コロニー

一生ものにできる耐久性

軽量で強度が高い:チタンは、すべての金属の中で最も強度対重量比が高いので、一般的な鋼鉄のような一般的な金属よりも、少ない質量で十分な強度を得られます。そのため、飛行機のエンジン、ドーム球場の屋根、橋梁、人工関節などに広く用いられています。

耐腐食性が高い:チタンの腐食速度は非常に遅く、海水に4000年間漬けていても表面の海水浸透は1㎜未満です。
ユーザーフレンドリーなデザイン

ユーザーが手に持っても熱くないようボトル本体は真空二重構造でできています。

漏れや劣化の防止にも配慮してデザインされているほか、無駄なコーティング等を省いてチタンそのものの質感を楽しめるようにしました。
チタンの重さはステンレスの半分

「Micro Therma」の重量は126gしかありません。一般的な多くの文庫本よりも軽い水筒です。
同じサイズのステンレス製タンブラーに比べれば、重量は半分ほど。ポケットに入れているのを忘れているほどの手軽さを感じることができます。

ミニマリズムを追求したデザイン

「Micro Therma」はミニマリズムを追求したデザイン性が特徴です。ポケットから出す際も、一見サーマボトルに見えないほどシンプル。

様々なファッションにも自然とマッチするので、腕時計のように手放せないアイテムになります。
純チタン製サーモボトル「Micro Therma」



製品名:Micro Therma
サイズ:高さ14.8㎝ x 直径4.6㎝
重量:126g
容量:130ml
構造:チタン真空二層構造(ダブルウォール)
特徴:蓋、ボディは医療グレード純チタン製
ボトル底にシリコン製の滑り止めパッド
■特定商取引法に関する記載
◯ 販売事業者名: 株式会社メディアジーン
◯ 事業者の所在地:〒150-0044 東京都渋谷区円山町23−2 アレトゥーサ渋谷 6F
◯ 事業者の連絡先:Tel: 03-5784-6702 メール: contact@titano.jp
※こちらでは当該製品に対するお申し込み、質問等は受け付けておりません。
◯ リターン価格:各リターン記載の通り
※ 商品内容に関してはリターン欄記載の通り
※ リターン価格とは別にcampfire(machi-ya)のシステム利用料として1支援毎に200円(税別)が支援者様の負担となります。尚、このシステム利用料はcampfireが受け取るもので、当社が受領するものではございません。
◯ 申込期限:当ページ記載のプロジェクト終了期限通り
◯ 支払い方法:クレジットカード払い(Visa/Mastercard/JCB/Diners Club/American Express)/コンビニ払い(全国の主要コンビニエンスストア)/銀行振込(銀行ATM・ネットバンキング)/auかんたん決済/ソフトバンクまとめて支払い・ワイモバイルまとめて支払い/ドコモ払い
◯ 支払い時期 :当プロジェクトは「All-in型」の為、目標達成の如何に問わず、ご契約が成立しリターンをお届けします。その為、お申込みと同時にご利用の決済方法に準じてご請求となります。
◯ 引渡し時期: 各リターン詳細に記載の発送予定月を引き渡し時期とします。但し、開発・生産状況によって遅れが生じる場合がありますのでその際は当プロジェクトページ内の「活動報告」または購入者へのメール等で連絡します。
◯ キャンセル・返品: 当プロジェクトは「All-in型」の為、お申込み完了をもって契約が成立いたします。その為、お客様都合による返品・キャンセルはできませんのでご注意ください。尚、製品到着後に破損や初期不良がある場合には交換させていただきますので「メッセージで意見や問い合わせを送る」から、または納品書記載の連絡先までお問い合わせください。
※上記以外の事項に関しては、お取引の際に請求があれば遅延なく提示いたします。
最新の活動報告
もっと見る
TITANOの新製品「Therma 280 & Therma 380」発売のお知らせ
2021/07/26 14:53Micro Thermaをご支援いただいた皆様日頃からTITANO製品をご支援いただきありがとうございます。この度、TITANOの新製品としてチタン製ボトル「Therma 280 & Therma 380」をmachi-yaにて先行発売することになりましたので、ご連絡いたします。下記ページから「お気に入り」登録をしておくと、公開と同時にメールに通知がされるのでぜひお気に入りボタンのクリックをお願いします!Therma 280 & Therma 380https://camp-fire.jp/projects/view/446655Thermaは、日米シリーズ累計6900万円以上を販売し、大変注目を集めたチタン製のボトルです。ボトルと言えばステンレスが一般的な素材ですが、Thermaは医療グレードの純チタンを全面に採用。チタンの軽量性、強度はもちろん、素材ならではの天然の抗菌性、金属臭を抑えて、飲み物の味を変えない無味無臭の特性など、チタン素材の強みを存分に活かした金属製ボトルです。高度なエンジニアリング技術を駆使し、チタン素材でありながら真空二重構造を実現。一般的なまほうびん構造の水筒の保冷・保温性能を有しています。今回は、日常生活での使いやすさを考慮に入れて、280mlサイズと380mlサイズの2サイズを展開いたします。280mlは小さいペットボトルとほぼ同じサイズ。380mlは一般的な250mlのアルミ缶の容量が比較的余裕を持って入るサイズ、となっています。↑Therma 280↑Therma 380プロジェクトの公開日は2021年7月30日(金)の午前10時、となっています。個数限定のお得なリターンもご用意しておりますので、ぜひ下記プロジェクトページをご確認ください。個数限定ですので、早いもの勝ちですよ!ちなみに、下記ページから「お気に入り」登録をしておくと、公開と同時にメール通知がされるので便利です!ぜひボタンのクリックをお願いします。Therma 280 & Therma 380https://camp-fire.jp/projects/view/446655以上、よろしくお願いいたします。TITANO もっと見る発送目処のご連絡
2021/06/10 16:32支援者の皆様この度は、TITANOのMicro Thermaをご支援いただき誠にありがとうございました。配送の遅延が発生していること大変申し訳ございません。現在発送のための手続きを進めておりまして、来週月曜日(6月14日)には日本郵政に引き渡し及び、発送ができる目処が立ちました。お届けまで、もう少々お待ちいただければと思います。よろしくお願いいたします。TITANO もっと見る国内配送拠点への到着のお知らせ
2021/06/07 18:17こちらの活動報告は支援者限定の公開です。





いつ頃手に入りますか?